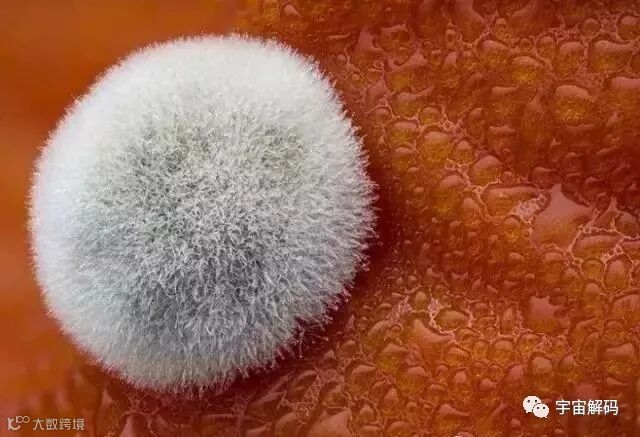

那些看不到的小东西,
放大10倍甚至100倍会是什么样子?
前不久,小编到微观世界潇洒走了一回,还拿到了微观圈最新出炉的排行榜,快来看看前十名都是谁吧!
第一名

上榜理由:
这是一只绦虫的骇人照片。
那是它的眼睛吗?
不,是吸盘。
惊讶指数:★★★★★
第二名

上榜理由:
像不像吃豆人?
这张团藻正在释放新一代菌落。
(大家可以理解成细菌部落)
惊讶指数:★★★★★
第三名

上榜理由:
这是盲蜘蛛(也叫长腿蜘蛛)的眼睛
放大20倍后的效果。
小编认为,
光看这双大眼睛,就能把掠食者吓跑吧。
惊讶指数:★★★★★
第四名

上榜理由:
这看上去像不像一群五颜六色的气球?
实际上,
这是小鸡胚胎的睫状神经节
放大30倍时显示的单独标记的轴突。
惊讶指数:★★★★
第五名

上榜理由:
这是航海风格的睡衣图案?
其实,这些微小的“锚”
是海参皮肤中的小骨放大100倍后的效果。
惊讶指数:★★★★
第六名
上榜理由:
好想捏一捏这个毛球啊!
一个霉菌斑点与西红柿的红色表皮
形成鲜明对比。
惊讶指数:★★★★
第七名

上榜理由:
这是欧洲千里光的种子头,
一株寻常的草本植物
竟有如此精细的种子构造。
好神奇!
惊讶指数:★★★
第八名

上榜理由:
百合花粉的复杂结构放大63倍后长这样。
从小就这么好看,真是基因强大啊!
惊讶指数:★★★
第九名

上榜理由:
这是蝴蝶卵放大7.5倍后的效果,
看上去就像长着绒毛的小灯笼。
太可爱了!
惊讶指数:★★★
第十名

上榜理由:
这是由荷兰癌症研究所的工作人员
拍摄的景象,
展现了一个皮肤细胞产生的过量角蛋白
(具有结缔和保护功能的纤维状蛋白质)。
惊讶指数:★★★
原来微观世界这么有意思!

您若有融资需求 请点击阅读原文了解更多……






